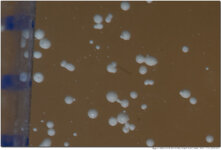
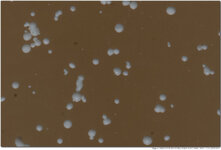

Jöwu
Themenersteller
Hallo (vormalige) Sigma-105-OS-Besitzer!
Ich stehe vor etwa der gleichen Entscheidung wie Alex-60D im Februar 2018, siehe Thema "Canon EF 100 mm 2.8 Macro oder Sigma 105 mm 2.8 Makro" (https://www.dslr-forum.de/showthread.php?t=1867205). Habe mir das Thema durchgelesen, eine Frage bleibt allerdings offen: Wie sind Eure persönlichen Erfahrungen mit dem Sigma 105 OS für den Makro-Bereich? (Das, was im Thema stand, waren, wenn ich es richtig einschätze, nur Wiedergaben von Testergebnissen Dritter.)
Hat jemand von Euch (vormaligen) Besitzern das Objektiv nicht mehr, weil es seine Erwartungen nicht erfüllt hat? (In mehreren Nutzerberichten bei Amazon stand zum Beispiel etwas von ungewöhnlich lautem AF und auch IS.)
Oder ist jemand von Euch mit gutem Grund seit Jahren begeistert?
Persönliche Erfahrungen würden mir sehr bei einer Kaufentscheidung helfen! (Zu den alternativen Canon 100mm 2,8 mit oder ohne L ist im genannten Thema schon genug gesagt worden, zu Tamron mit IS allerdings noch nicht.)
Danke im Voraus
Jörg
Ich stehe vor etwa der gleichen Entscheidung wie Alex-60D im Februar 2018, siehe Thema "Canon EF 100 mm 2.8 Macro oder Sigma 105 mm 2.8 Makro" (https://www.dslr-forum.de/showthread.php?t=1867205). Habe mir das Thema durchgelesen, eine Frage bleibt allerdings offen: Wie sind Eure persönlichen Erfahrungen mit dem Sigma 105 OS für den Makro-Bereich? (Das, was im Thema stand, waren, wenn ich es richtig einschätze, nur Wiedergaben von Testergebnissen Dritter.)
Hat jemand von Euch (vormaligen) Besitzern das Objektiv nicht mehr, weil es seine Erwartungen nicht erfüllt hat? (In mehreren Nutzerberichten bei Amazon stand zum Beispiel etwas von ungewöhnlich lautem AF und auch IS.)
Oder ist jemand von Euch mit gutem Grund seit Jahren begeistert?
Persönliche Erfahrungen würden mir sehr bei einer Kaufentscheidung helfen! (Zu den alternativen Canon 100mm 2,8 mit oder ohne L ist im genannten Thema schon genug gesagt worden, zu Tamron mit IS allerdings noch nicht.)
Danke im Voraus
Jörg
Zuletzt bearbeitet: